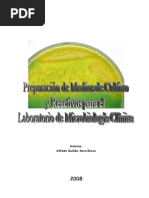

0% encontró este documento útil (0 votos)
273 vistas36 páginasPatología y Tratamientos de Amígdalas
Este documento describe la anatomía y patología del anillo de Waldeyer, que incluye las amígdalas, adenoidas y tejido linfoide asociado de la nasofaringe, orofaringe e hipofaringe. Describe las infecciones bacterianas y virales más comunes como la faringitis estreptocócica aguda, la angina de Vincent y la candidiasis orofaríngea. También cubre las complicaciones como el absceso periamigdalino e infecciones cervicales profundas, así como la hipertrofia adenoamig
Cargado por
Jorge Armando Nuñez MoralesDerechos de autor
© © All Rights Reserved
Nos tomamos en serio los derechos de los contenidos. Si sospechas que se trata de tu contenido, reclámalo aquí.
Formatos disponibles
Descarga como PPTX, PDF, TXT o lee en línea desde Scribd
0% encontró este documento útil (0 votos)
273 vistas36 páginasPatología y Tratamientos de Amígdalas
Este documento describe la anatomía y patología del anillo de Waldeyer, que incluye las amígdalas, adenoidas y tejido linfoide asociado de la nasofaringe, orofaringe e hipofaringe. Describe las infecciones bacterianas y virales más comunes como la faringitis estreptocócica aguda, la angina de Vincent y la candidiasis orofaríngea. También cubre las complicaciones como el absceso periamigdalino e infecciones cervicales profundas, así como la hipertrofia adenoamig
Cargado por
Jorge Armando Nuñez MoralesDerechos de autor
© © All Rights Reserved
Nos tomamos en serio los derechos de los contenidos. Si sospechas que se trata de tu contenido, reclámalo aquí.
Formatos disponibles
Descarga como PPTX, PDF, TXT o lee en línea desde Scribd